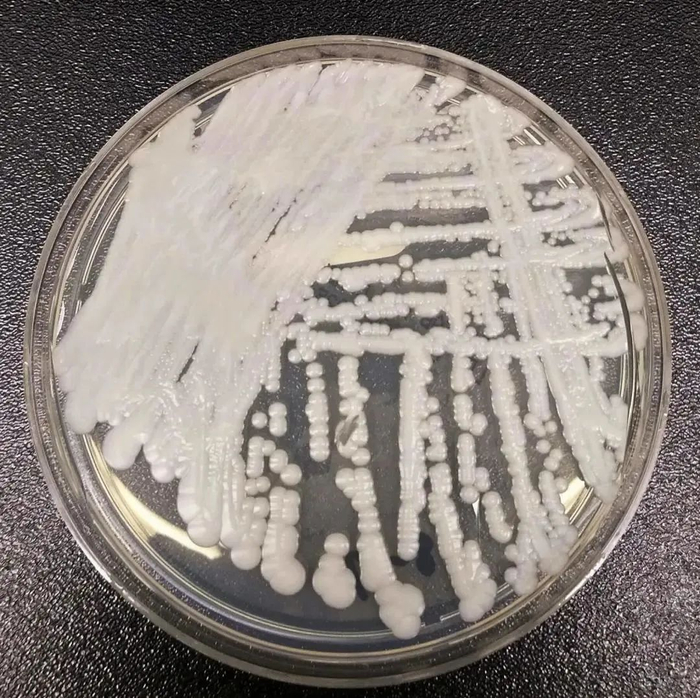
▲培养皿中培养的耳念珠菌菌株（来源：视觉中国）

感染者致死率高达60%,近半90天内死亡,耳念珠菌到底可不可怕?我们能做什么?
近日,美国疾病控制和预防中心(CDC)发布信息,耳念珠菌正在以“惊人的速度”传播,目前已遍布美国一半以上的州,成为紧迫的公共卫生威胁。
美国近一半感染者90天内死亡
CDC称,近一半感染了耳念珠菌的患者会在90天内死亡,而且在受感染的住院病人中,估计有30%至70%的人最终会死亡。但CDC真菌疾病部门的医务官员莱曼说,该机构不清楚有多少死亡可以直接归咎于这种真菌。
根据研究,耳念珠菌可导致免疫系统较弱的人患上严重疾病,且具有耐药性。从2019年到2020年,美国的感染人数增加了59%,达到756人,2021年感染人数增加了95%,达到1471人,2022年感染人数进一步上升,达到2377人。纽约流行病专家瓦利德·贾韦德表示,此类真菌具有极端生存和繁殖能力。
据悉,耳念珠菌能停留较长时间,并且能通过病人和被污染的物体传播。“由于真菌会在表面停留很长时间,因此对医院进行彻底清洁具有挑战性。医疗机构常用的一些消毒剂对这种真菌不起作用。”莱曼说。
▲培养皿中培养的耳念珠菌菌株(来源:视觉中国)
美国官员说,新冠疫情很可能加剧了耳念珠菌的传播。因为随着公共卫生部门对新冠病毒的关注度提升,导致对耳念珠菌筛查的重视程度降低。此外,耳念珠菌容易附着在护理服、手套和其他个人防护装备上。在理想情况下,这些装备应该经常更换,但由于疫情期间供应短缺,这些装备经常被重复使用,可能也加速了真菌传播。
我国此前曾有病例
在我国,2019年已有18例患者感染耳念珠菌 。2022年6月,耳念珠菌在某院重症科病区内传播,1例患者发生耳念珠菌败血症医院感染,最终抢救无效死亡。

▲耳念珠菌的3D插图(来源:视觉中国)
2018年,在北京大学人民医院1例肾病综合征患者的肺泡灌洗液中检测出耳念珠菌,这是我国首例“耳念珠菌”感染病例,但在该患者其他部位及周围环境中未检出耳念珠菌。截至2020年8月,中国公开报道的耳念珠菌感染病例报道数量已有25例。
接触传播是耳念珠菌引起医院感染的主要原因,一旦发生耳念珠菌医院感染,极易在病区,甚至医院内播散。
2022年6月6日我国某院重症科1例长期住院患者(章某)检出耳念珠菌,随后在该重症科14例在院患者进行筛查发现,其中8例患者检出耳念珠菌9株。
而章某既往有2型糖尿病病史多年,长期滞留重症病房,免疫力低下,最终出现耳念球菌败血症,抢救无效死亡。但其他7例检出耳念珠菌的重症患者,均无临床正常,考虑为定植菌。经过采取积极防控措施,7例定植患者后期复查均转阴,未在病房内发生暴发流行。
发现中国首例耳念珠菌感染病例的北京大学人民医院教授王辉表示,并非所有类型的耳念珠菌都具有“超级真菌”级别的杀伤力。
王辉介绍,耳念珠菌最早在2009年由日本学者在耳道中分离得来。国外研究者发现这种致病菌的某些菌株类型常对多种抗真菌药物耐药,且在医院环境下具有很强的克隆传播性,可以在患者和环境间广泛传播,极易造成集中暴发,死亡率高达33%~60%。
由于某些类型的耳念珠菌的多重耐药性、传播性强和死亡率高的特点类似于多重耐药菌,人们就仿照“超级细菌”的叫法,称其为“超级真菌”。
一般人不易感染
不同菌株在细胞形态、毒力和致病性等方面具有很大差异,现有研究也显示,日本分离的第一株耳念珠菌和我国近年来分离的菌株均未表现出多重耐药。因此,将所有耳念珠菌都笼统地称作“超级真菌”并不科学。”王辉说。
王辉表示,尽管耳念珠菌的致病机制并未完全阐明,但其作致病性与白念珠菌有很多相似之处,但其整体毒力弱于白念珠菌。蛋白酶、磷脂酶、摄铁能力等是真菌入侵和感染宿主的重要“武器”,但不同菌株的耳念珠菌的武器“杀伤力”差异大,致病性也不同。
大多数耳念珠菌感染都发生在医院和养老院等医疗机构,其感染途径通常是接触被污染的物体表面或通过人际传播。

(图源:视觉中国)
该真菌有两种影响人体身体的方式:
第一,这种真菌可以生存在人类皮肤、直肠或口腔等特定区域,这一过程被称为“无症状定植”。患者不会表现出感染症状,但可以将真菌传播给其他人。
第二,这一真菌也可能进入血液或伤口,导致严重的侵入性感染。在这一过程中,患者会出现典型的感染症状,如发烧和发冷。
不过耳念珠菌并不可怕,一般人不易感染。并非所有的耳念珠菌都是超级真菌,只有对多种真菌药物耐药,并有较强的致病性的耳念珠菌才被认为是“超级真菌”。
中国疾控中心传染病预防控制所助理研究员龚杰表示,耳念珠菌不感染健康人,不可能在健康人中大规模流行。这是一种医院内感染真菌,一般仅在住院病人(特别是本身有基础疾病的人群)中,通过人与带菌者或带菌物体的接触传播。
感染耳念珠菌的危险人群一般有以下几类:
1.长期使用广谱抗生素和抗真菌药物的人群。
2.使用中心静脉导管、呼吸管、饲管和膀胱导管的住院病人。
3.长期住院的病人。
4.免疫系统缺陷的病人。
简单地说,这种超级真菌一般只发生在本身有基础疾病的住院病人身上,正常人不易感染。即使是那些可能接触患者的人,感染耳念珠菌的风险也十分低。
北京协和医院耳鼻喉科主任医师蒋子栋提醒,“对于进入过疫区后回国的人,回国前、回国后,一定要认真清洗身体与衣物,并进行消毒,同时,不要接触有免疫力缺陷和免疫力低下的人,最好不要到医院看病人。”
此外,对于预防耳念球菌早诊断非常重要。蒋子栋介绍,如果临床上,医生发现耳道出现感染、并伴有不明原因的高热、腹泻、呼吸困难的患者,一定要其转到上级专业检查机构进一步检查,不要误判、漏判,发现疑似患者,要采取相应隔离防控措施,才能避免大规模传播。
日常生活中保持良好的手部卫生(经常用皂液和流动水洗手),是预防耳念珠菌感染的重要方法。如果家庭成员中有感染耳念珠菌的患者,在探望照看病人时可以戴上一次性手套,探望病人后及时洗手,避免耳念珠菌传播。
整理/新媒体编辑 段大卫


